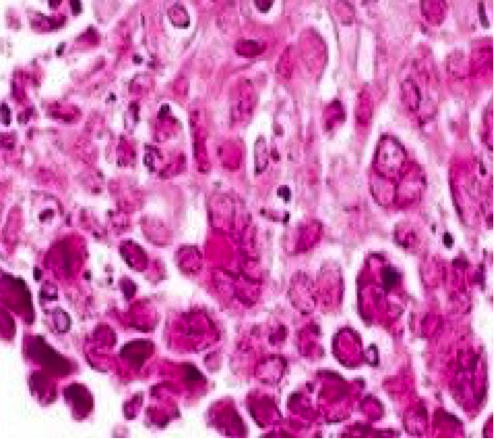
Fig 4

Peer Reviewed
Herpes Simplex Virus Esophagitis in an Immunocompetent Patient
Authors:
We’am Hussain, MD
Internal Medicine Resident, Wright State University, Dayton, Ohio
Drew Triplett, DO
Gastroenterology Fellow, Wright State University, Dayton, Ohio
Sangeeta Agrawal, MBBS
Professor of Internal Medicine; Gastroenterology Fellowship Director; Division Director, Gastroenterology, Wright State University, Dayton, Ohio
Citation:
Hussain W, Triplett S, Agrawal S. Herpes simplex virus esophagitis in an immunocompetent patient. Consultant. 2020;60(1):24-26. doi:10.25270/con.2020.01.00009
A 53-year-old man presented to the emergency department and was subsequently admitted to the medical ward with hematemesis, melena, and atypical chest pain, all occurring intermittently for the past few days. He described the chest pain as “burning” and reported that it was provoked by eating.
He had a history of cigarette smoking, alcohol dependence, gastroesophageal reflux disease, asthma, osteoarthritis, chronic obstructive pulmonary disease, and seizure disorder, as well as a remote history of cerebrovascular accident without long-term deficits. He was nonadherent to medications and medical care.
A gastroenterology consultation for odynophagia and chest pain was obtained on the day of admission.
At presentation, his vital signs were within normal limits, and his body mass index was normal at 23 kg/m2. Significant physical examination findings included anicteric sclera, poor dentition, and mild epigastric tenderness to palpation.
Laboratory test results of note included a low hemoglobin level of 13.7 g/dL, and serological test results were negative for HIV-1 and HIV-2 antibodies.
Abdominal ultrasonography scans showed mild diffuse fatty infiltration of the liver. Computed tomography (CT) scans of the abdomen showed mild circumferential mural thickening of the lower esophagus (Figures 1 and 2).

Figure 1. Abdominal CT, axial view, showing circumferential mural thickening of the lower esophagus.

Figure 2. Abdominal CT, coronal view, showing circumferential mural thickening of the lower esophagus.
Esophagogastroduodenoscopy (EGD) showed circumferential esophagitis of the distal 6 centimeters of the esophagus with ulcerative exudate, small hiatal hernia, and mild gastropathy (Figure 3). Histopathology results from esophageal biopsies from the edge of the ulcers showed herpes simplex virus (HSV), which is believed to have caused the patient’s severe esophagitis (Figure 4).

Figure 3. EGD showed ulcerative exudates.
Figure 4. Esophageal biopsy highlighted HSV.
He was started on acyclovir, 400 mg by mouth, 3 times per day for 1 week. His symptoms slowly improved over the next few days; his diet was advanced, and he was discharged home. The patient did not attend his gastroenterology clinic follow-up appointment and was lost to follow-up.
Discussion. HSV esophagitis (HSE) is an opportunistic infection that most commonly occurs in patients with defects in cell-mediated immunity. It occurs most frequently in immunocompromised patients with HIV or cancer, or in immunosuppressed patients who are being treated with chemotherapy, radiation, or corticosteroids. HSE in an immunocompetent person is a rare finding and is most commonly due to either primary disease or reactivation of a latent infection.1 Our patient had no clinical indication of immunosuppression, no leukocytosis, and no evidence of HIV infection.
HSV is a double-stranded DNA virus classified into 2 subtypes, HSV-1 and HSV-2. HSV-1 is the second leading cause of infectious esophagitis following candidiasis. HSV may affect all mucocutaneous sites and has been isolated from nearly all visceral sites; HSV usually spreads to visceral organs through viremia as primary disease and can cause a multiorgan infection. However, HSV also can spread to the esophagus through direct extension of infection from the oropharynx or by reactivation of HSV, traveling down the vagus nerve toward the esophagus.2 Patients most commonly present with an acute onset of esophageal symptoms, with a variety of presentations including odynophagia, dysphagia, fever, pharyngitis, chest pain, myalgia, and poor oral intake.
Definitive diagnosis is based on endoscopic biopsy samples for tissue examination and virus isolation. Endoscopically, HSE appears as erythema and ulcers in the mid or distal esophagus with exudates.3 Endoscopy alone is not sufficient to make the diagnosis, however, since HSE can be confused with cytomegalovirus infection, candidiasis, or peptic esophagitis.4 Histopathology tests from the esophageal biopsy will show inflammation with multinucleated giant cells with Cowdry type A intranuclear inclusions, which are eosinophilic intranuclear inclusions, and nuclear chromatin with a ground-glass appearance.
HSE in immunocompetent patients usually resolves over 2 weeks without therapy. However, potential complications include gastrointestinal tract bleeding, spontaneous esophageal perforation, and mediastinitis.5 However, if acyclovir is started during the symptomatic period of HSE, complications may be prevented, and the resolution of symptoms accelerated.6
In summary, HSE should be suspected in otherwise healthy individuals who present with symptoms suggestive of esophagitis, such as dysphagia, odynophagia, and chest pain, and particularly in individuals who have ulcerations in the mid or distal esophagus on endoscopy. Biopsy samples should be taken endoscopically from the edge of the ulcers, and histopathology should be examined microscopically. It is critical to rule out causes of immunodeficiency such as HIV infection in patients who present with HSE. Starting antiviral therapy promptly in immunocompetent patients helps to shorten the duration of illness and reduces the probability of potential serious complications.
- Ramanathan J, Rammouni M, Baran J Jr, Khatib R. Herpes simplex virus esophagitis in the immunocompetent host: an overview. Am J Gastroenterol. 2000;95(9):2171-2176.
- Corey L, Spear PG. Infections with herpes simplex viruses. N Engl J Med. 1986;314(12):749-756.
- Agha FP, Lee HH, Nostrant TT. Herpetic esophagitis: a diagnostic challenge in immunocompromised patients. Am J Gastroenterol. 1986;81(4):246-252.
- Galbraith JC, Shafran SD. Herpes simplex esophagitis in the immunocompetent patient: report of four cases and review. Clin Infect Dis. 1992;14(4):894-901.
- Cronstedt JL, Bouchama A, Hainau B, Halim M, Khouqeer F, al Darsouny T. Spontaneous esophageal perforation in herpes simplex esophagitis. Am J Gastroenterol. 1992;87(1):124-127.
- Desigan G, Schneider RP. Herpes simplex esophagitis in healthy adults. South Med J. 1985;78(9):1135-1137.
